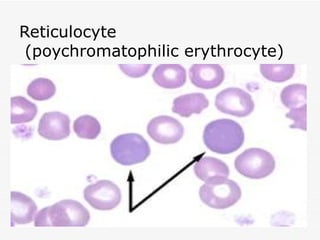
Reticulocyte
 (poychromatophilic erythrocyte)
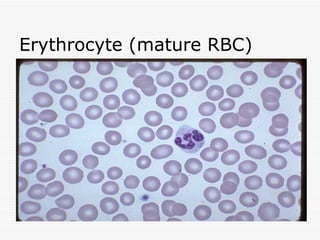
Erythrocyte (mature RBC)
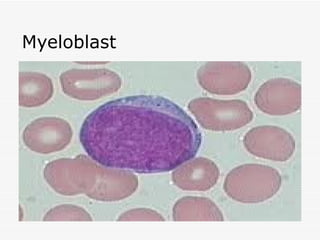
Myeloblast
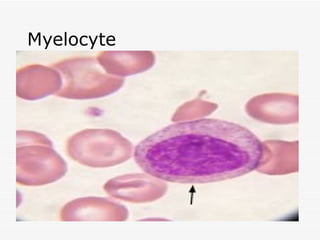
Myelocyte
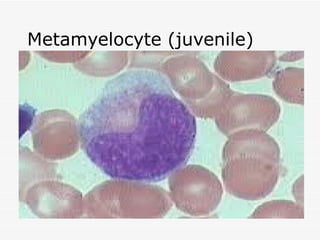
Metamyelocyte (juvenile)
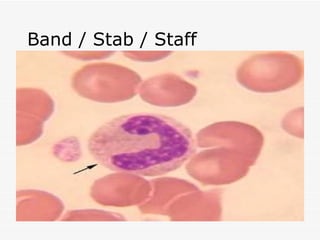
Band / Stab / Staff
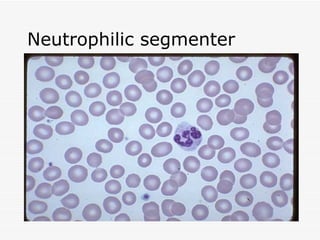
Neutrophilic segmenter
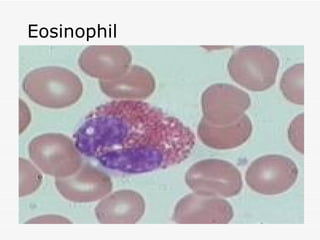
Eosinophil
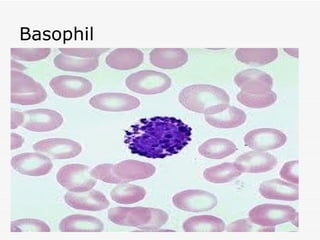
Basophil

This document discusses hematopoiesis, the formation of blood cells. It presents two main theories: the monoplastic theory which states all blood cells originate from one stem cell, and the polyplastic theory which suggests different blood cell types originate from different stem cells. The stages of blood cell development are described starting from the embryonic stage through the hepatic and medullary stages where development occurs in the bone marrow. The processes of erythropoiesis and granulopoiesis, leading to the production and maturation of red blood cells and white blood cells, are outlined in detail through their characteristic cell types.